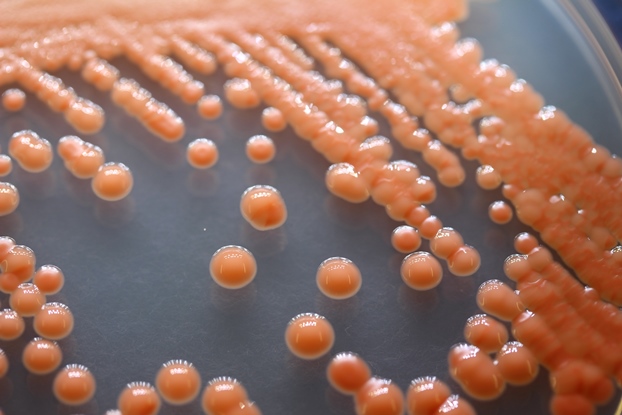

Фотографии дрожжей родоторула

Раздел: Природная галерея